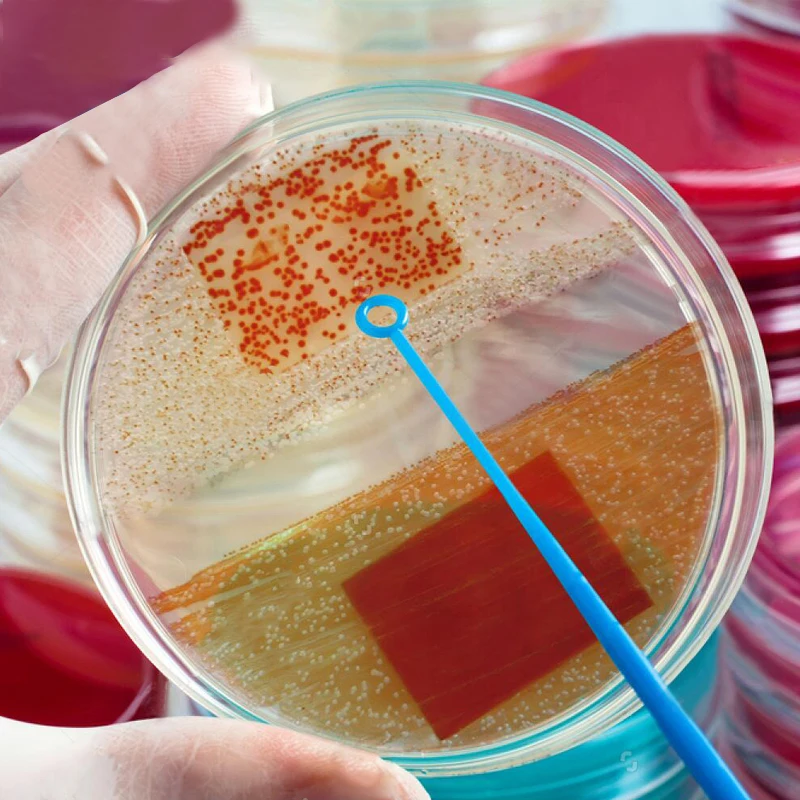

Одноразовая Стерильная пластиковая чаша Петри, прозрачная лабораторная тарелка для культивирования, 10 шт.лот, 120 мм 




956,06₽
В наличии!
Quality first and Integrity first Store - Надежность 96%
Более 60 подписчиков, дата открытия магазина 29.08.2020
- Положительные оценки: 98% (106)
- Соответствие описанию: 96%
- Отвечает на сообщения: 96%
- Скорость отправки: 94%
Последнее обновление: 07.05.2022
ZS 6 шт.лот пирсинг в нос из нержавеющей стали CZ хрустальное сердц...
383,04₽
Последнее обновление: 27.05.2022
Рыболовная приманка HYBOLAN, металлическая блесна-ложка, жесткие пр...
89,84₽
Последнее обновление: 12.10.2024
5 шт.компл. треугольный резак для печенья из нержавеющей стали форм...
63,65₽
Последнее обновление: 03.03.2022
Натуральная Бирюза Кольца Позолоченные золотые линии бирюзовые регу...
71,79₽
Последнее обновление: 23.04.2022
Чокер из нержавеющей стали с эмалью и бусинами, длинная цепочка 45 ...
325,61₽
Последнее обновление: 10.03.2022
1 шт. 14015 140*15 мм Светодиодная лента COB источник светильник 12...
107,23₽
Последнее обновление: 21.09.2024
Кулон с ананасом браслет с милым фруктовым полый браслет женских ук...
64,38₽
Последнее обновление: 13.04.2022
Женский вязаный крючком топ-бикини ручной работы, цельный женский к...
312,28₽
Последнее обновление: 02.03.2022
Одноразовая Стерильная пластиковая чаша Петри, прозрачная лаборатор...
1 307,56₽
Последнее обновление: 05.09.2024
Последнее обновление: 10.04.2022
Женский вязаный крючком Топ Бикини ручной работы цельный женский ку...
941,52₽
Последнее обновление: 18.03.2022
Блестящий фианит медный браслет с подвеской в виде сглаза для женщи...
191,12₽
Последнее обновление: 18.09.2024
JINAO, футболки в стиле хип-хоп с покрытием, высокое качество, 18 д...
882,02₽
Последнее обновление: 12.09.2024
10 шт./лот 120 мм одноразовая Стерильная пластиковая чаша Петри прозрачная лабораторная культура блюдо
10 шт./пакет, 1 упак./лот.
Название продукта: пластиковая чаша ПетриМатериал: полистирол PSИспользование продукта:1. Лабораторный анализ;2. Общая культура3. Напряженная культура и так далееПримечание: окись этилена стерилизована


Вопросы еще не задавались...
-
Вес логистики0.600
-
Каждая упаковка10
-
КлассификацияЧашки Пертри с крышками
-
Минимальная единица измерения100000015
-
Название брендаНет
-
Номер модели120mm 10pcs
-
Объем120 мм
-
Продано Вsell_by_lot
-
ПроисхождениеКитай
-
Размер логистики - высота (см)11
-
Размер логистики - длина (см)11
-
Размер логистики - ширина (см)22